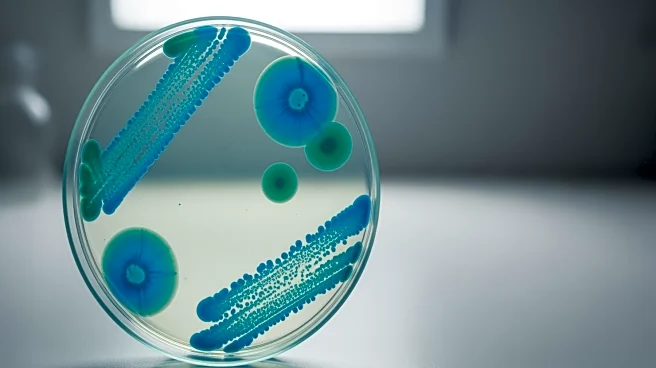
Chronic Diarrhea Linked to Uncommon C. diff Infection in Elderly Patient

What's Happening?
In Munich, Germany, a debate has intensified over the restoration of a surfable wave in the Eisbach river, located in the city's English Garden. The wave, a popular spot for surfers, disappeared in October after city workers cleared sediment and debris
from the riverbed. Over the Christmas holiday, an unauthorized beam was installed to recreate the wave, allowing surfers to enjoy the river once again. However, city authorities removed the beam, citing safety concerns. The city's climate and environment department emphasized the illegality and potential danger of the structure, especially following a tragic incident in May where a surfer died after being trapped underwater. The city is consulting with an engineering professor to find a safe solution, but surfers argue that the process is being hindered by excessive conditions imposed by the city.
Why It's Important?
The situation highlights the ongoing tension between recreational use of public spaces and safety regulations. The Eisbach wave is a significant cultural and recreational feature in Munich, attracting both local and international surfers. The removal of the wave has sparked frustration among the surfing community, who feel that the city's slow response and stringent conditions are stalling efforts to restore the wave. This incident underscores the challenges cities face in balancing public safety with the preservation of cultural and recreational activities. The outcome of this debate could set a precedent for how similar situations are handled in other urban areas with natural recreational sites.
What's Next?
The city of Munich is expected to continue discussions with the surfing community and experts to find a viable solution for restoring the Eisbach wave safely. The involvement of an engineering professor suggests that technical assessments and potential modifications to the riverbed or surrounding infrastructure may be considered. The surfing community is likely to continue advocating for a swift resolution, possibly organizing further demonstrations or negotiations to expedite the process. The city's response and any proposed solutions will be closely watched by both local residents and the international surfing community.
Beyond the Headlines
This incident raises broader questions about the management of natural resources and public spaces in urban environments. It highlights the need for cities to develop frameworks that accommodate recreational activities while ensuring public safety. The debate also touches on the cultural significance of such sites and the role of community engagement in decision-making processes. As urban areas continue to grow, finding sustainable ways to integrate recreational spaces into city planning will become increasingly important.